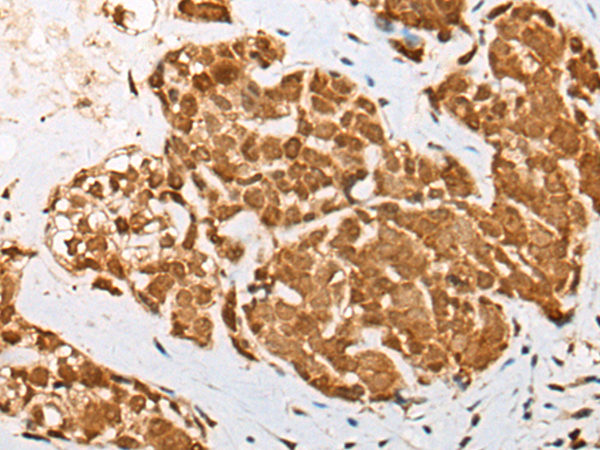

中文名稱:兔抗ATN1多克隆抗體
|
Background: |
Dentatorubral pallidoluysian atrophy (DRPLA) is a rare neurodegenerative disorder characterized by cerebellar ataxia, myoclonic epilepsy, choreoathetosis, and dementia. The disorder is related to the expansion from 7-23 copies to 49-75 copies of a trinucleotide repeat (CAG/CAA) within this gene. The encoded protein includes a serine repeat and a region of alternating acidic and basic amino acids, as well as the variable glutamine repeat. Alternative splicing results in two transcripts variants that encode the same protein. |
|
Applications: |
ELISA, IHC |
|
Name of antibody: |
ATN1 |
|
Immunogen: |
Synthetic peptide of human ATN1 |
|
Full name: |
atrophin 1 |
|
Synonyms: |
B37; HRS; NOD; DRPLA; D12S755E |
|
SwissProt: |
P54259 |
|
ELISA Recommended dilution: |
5000-10000 |
|
IHC positive control: |
Human thyroid cancer and human ovarian cancer |
|
IHC Recommend dilution: |
40-200 |

購(gòu)物車
幫助
021-54845833/15800441009
